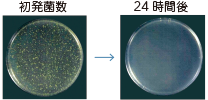
独自のメッシュボトム構造で清潔 黄色ブドウ球菌に対する抗菌性
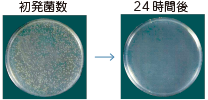
独自のメッシュボトム構造で清潔 大腸菌に対する抗菌性

電動ヘッドレスト機能搭載ベッド

正しい姿勢とポジショニングに焦点を当てて開発されました。
看護者さまの課題も解決できるように「スムーズな搬送性」や「最高床高」等、様々な機能が搭載されています。
オープン価格


製品機能・特長
電動ヘッドレスト機能で、頭頸部の角度を0〜30°(電動・手動式)の範囲で
調節することができます。

写真はWRXシリーズ
電動ヘッドレスト機能の
6つのポイント

1
誰でも簡単に
頭頸部のポジショニングが可能
誰でも簡単にポジショニングができ、業務の効率化に貢献します。
従来の頭頸部のポジショニング
<クッションやタオルを重ねて、頭頸部を調整>
身じろぎでクッションやタオルがずれるため、その度に調節が必要で看護業務の負担に

▼
電動ヘッドレスト機能を使用した
頭頸部のポジショニング
身じろぎでずれる事がなく、都度の調節の手間が省けます。
また、ポジショニングの再現が容易です。

ボタン1つで簡単に頭頸部を調節
閉じる

2
誤嚥リスクの低減
電動ヘッドレスト機能を活用することで、誤嚥しにくい「頸部前屈位姿勢」をボタン1つで簡単につくれます。
電動ヘッドレスト機能 未使用時 <頸部伸展位>
咽頭と気管が直線となり、食物が気管に入りやすい

写真はWRXシリーズ
▼
電動ヘッドレスト機能 使用時
食塊の通路が広がり、嚥下反射が起こりやすい

写真はWRXシリーズ
誤嚥リスクを低減する[頸部前屈位姿勢]
閉じる

3
床ずれリスクの低減
電動ヘッドレスト機能を活用することで体圧が分散され、床ずれリスクを軽減します。

写真はWRXシリーズ
電動ヘッドレストを使用することで、臀部への圧力が軽減します。

電動ヘッドレスト機能を使用することで、接点が増えるため体圧が分散されます。

閉じる

4
背圧の軽減
電動ヘッドレスト機能を使用することで、接点が増え体圧が分散・荷重が前へ移動するため、背上げ時の背中の圧迫感を軽減します。

写真はWRXシリーズ
閉じる

5
呼吸が楽になる姿勢をサポート
姿勢変化により横隔膜が下がり、呼吸が楽になる姿勢をサポートします。
ご利用者様の声
電動ヘッドレスト機能を使用した方が断然話しやすい。
喉が引っ張られる感じが無くなり、とても楽。
話していても苦しくない。
閉じる

6
コミュニケーションが取りやすい
電動ヘッドレスト機能を使用することで、目線が前を向くため、
目が合いやすくコミュニケーションを取りやすくなります。
ご利用者様の声
目線が前向きになり視線を合わせやすく、
よく話すようになり、笑顔が増えた。
本を読むときや、TVを見るときにも便利。
閉じる
軽くて握りやすく、シンプルで操作しやすい手元スイッチで
ご利用者様の煩わしさを極力低減しました。

付属のナースロックキーを使い、手元スイッチ裏側の3つのロック機能を活用できます。
ご利用者様ご自身で操作することが不都合な場合などの安全対策にご活用ください。

見やすさを意識した配色で動作ごとに色分けをしています。
また、上がる・下がるボタンや各動作部分には突起を設けているため、指で識別できるようになっています。

ベッドに内蔵されたセンサーにより、ベッドをお使いの方の起き上がり・離床・徘徊等の状態を検知し、分岐ボックスを介して現在お使いのナースコールにお知らせします。
センサーの設定は4つのボタンから選んで押すだけの簡単操作です。


背上げ機構

背上げ時に背ボトムの支点が後ろにスライドする「スイングバック機能」により、腹部及び背部の圧迫と前ずれを軽減します。

写真はWRXシリーズ


閉じる

省スペース設計

ベッド本体やパーツのコンパクト設計にこだわり、省スペース化を実現しました。
居室での動線確保はもちろん、オペ室の前室などの決められたスペースに設置するとき、従来より空きスペースを気にすることなく設置することができます。
また、エレベーター等の狭いスペースにもスムーズに搬送する事ができます。

[ WRXシリーズ ]
樹脂H/Fボードを使用した場合:ベッド総全長210cm、ベッド全幅94cm
木製H/Fボードを使用した場合:ベッド総全長212cm、ベッド全幅96.5cm
他シリーズについては各製品(仕様)ページをご覧ください。
閉じる

垂直ハイロー

ベッドが垂直に昇降する機構を採用することによって、壁や医療機器に接触するリスクが軽減されました。
また、サイドテーブルの使用可能域を広く確保しているため、端座位をとる際、サイドテーブルをベッドの足側に移動するだけで離床するスペースを確保できます。

写真はWRXシリーズ
従来のベッドは昇降時に頭側・脚側に約7〜8cmスイングし、壁や医療機器に接触するリスクがありました。
また、スイング幅分のスペースを確保する必要があるため、動線の確保が難しい場合もありました。
垂直ハイローではスイング幅を取らない為、居室を有効に活用することが出来ます。

従来のベッド(4床部屋)の場合
頭側とスイング分の合計で約34〜36cm お部屋が狭くなっていました。
閉じる

低床設計

床からボトム上面までの高さを低く設計しているので、ベッドサイドで端座位をとるときに足底が床につきやすく、立ち上がる際の転倒予防につながります。万一ベッドから転落しても、低床のため衝撃が大幅に緩和されます。

写真はWRXシリーズ
閉じる

フリーホイール機構

各ボトムとモーター駆動部が連結していないので、万が一各ボトムの下に挟まれた場合でも、モーターの力は加わらない構造になっています。

ボトムやマットレス、寝具、ご利用者様自体の重さはかかります。
閉じる

業界最高レベルの床高


写真はWRXシリーズ
低床を保持しながらも、上昇時の最高床高は業界最高レベルを実現しました。
ベッド上での看護作業の際に、腰に負担のかかる介助作業を極力軽減しました。
[ WRXシリーズ ]
φ12.5低床タイプ 最高床高68cm /
φ12.5リフト対応タイプ最高床高対応71cm
他シリーズについては各製品(仕様)ページをご覧ください。

閉じる

メッシュボトム/
抗菌粉体焼付塗装

いつも清潔で、安心してお使いいただけるシーホネンス独自のメッシュボトム構造を採用。通気性に優れているため、浸透する湿気を下側へ発散し、雑菌の繁殖やカビの発生を抑制します。
また、メッシュ部分は鋼線を交差させて溶接することで強度を高め、長期使用に耐える剛性と弾力性を兼ね備えています。

写真はWRXシリーズ
不特定多数の方が使用するベッドであることを考慮し、本体塗装には抗菌塗料を使用し、シーホネンス独自の抗菌粉体焼付塗装を行っています。
ブドウ球菌の中でも最も病原性の強い菌。
(化膿疾患、肺炎、敗血症、食中毒、とびひ等の剥離性皮膚炎の原因菌)
ヒトや動物の腸管内に広く常在している腸管常在菌叢を構成する菌。場合により日和見感染の原因菌になる。
測定:日本食品分析センター
閉じる

電源プラグホルダー

従来のベッドは、搬送時に電源コードが垂れ下がりキャスターに巻き込まれ、コードが断線したりプラグを傷める危険性がありました。
電源コードに加えて電源プラグも所定位置に収める事が出来るので、プラグの破損やコード断線リスクを軽減します。

写真はWRXシリーズ
意匠登録済
閉じる

大型キャスター

大型キャスターφ12.5cmで、転がり抵抗が少なく移動がスムーズです。
大きな車輪径なので使いやすく、走行面の凸凹や、エレベーターのギャップ等にも有効です。

写真はWRXシリーズ
閉じる

ヘッド・フットボード自動ロック機構

ヘッド・フットボードをベッド本体に差し込むだけでヘッド・フットボードのロックがかかります。
取り外す場合もワンタッチ操作でスピーディに取り外しができます。

写真はWRXシリーズ
閉じる



















シーホネンス株式会社
〒537-0001 大阪府大阪市東成区深江北三丁目10番17号
TEL:(06)6973-3471 / FAX:(06)6973-3440
Copyright (C) 2018 SEAHONENCE, INC. All Rights Reserved.


English site

